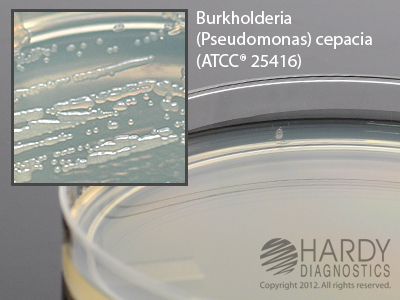
Pseudomonas Isolation Agar 18mL

Details
- Manufacturer: Hardy
- Mfr. Cat. # G219
- Brand Name: Hardy
Microbiology » Culture Media Plates
Pseudomonas Isolation Agar 18mL
Medix Item Code: HPI-G219
$68.88 per Pack
List Price: $90.60
You Save: $21.72 (24%)
Size: 10 per pack
Special shipping requirements
- Refrigerated - This item is refrigerated and must ship by air with ice.
Features
- For the selective isolation of Pseudomonas aeruginosa.
Description
Pseudomonas Isolation Agar, 18ml fill, 15x100mm plate, by Hardy Diagnostics, For the selective isolation of Pseudomonas aeruginosa. refrigerate on arrival.